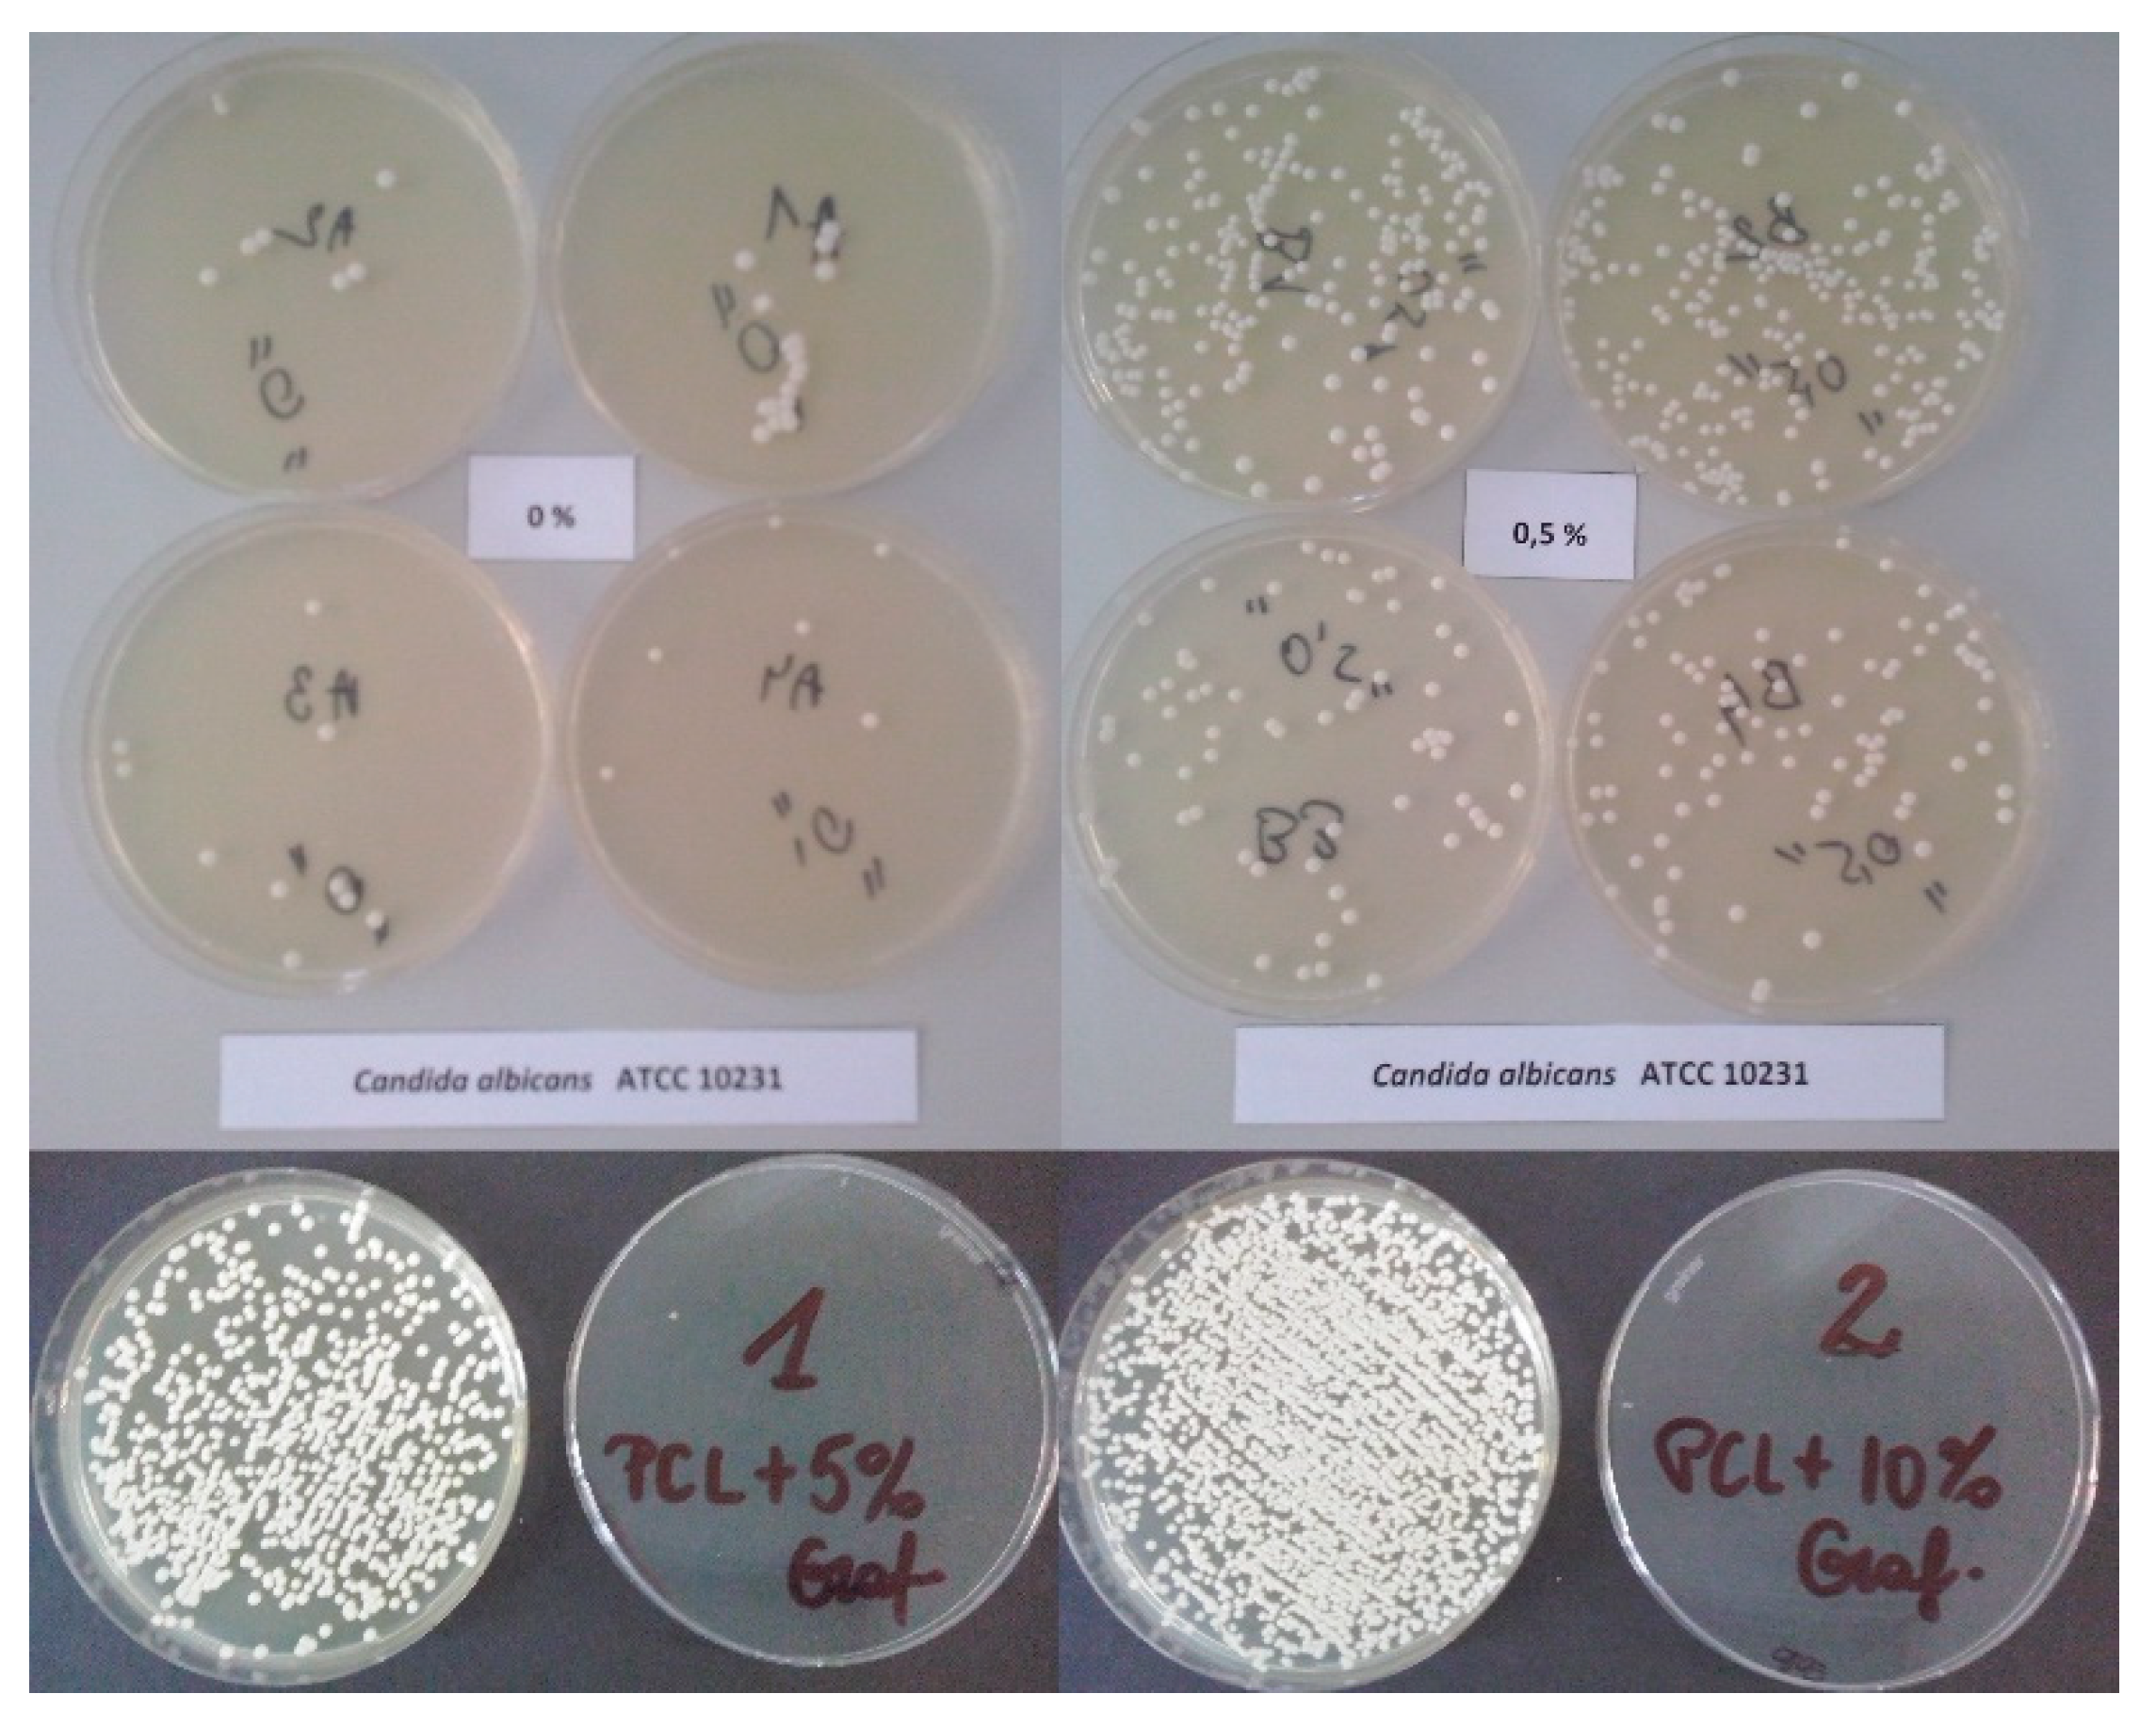
Ijms 23 10899 g005

The Influence of Graphene Content on the Antibacterial Properties of Polycaprolactone
Abstract
:1. Introduction
2. Results
3. Discussion
4. Materials and Methods
Sample Preparation
- (1)
- Staphylococcus aureus ATCC 25293
- (2)
- Escherichia coli ATCC 25922
- (3)
- Candida albicans ATCC 10231
5. Conclusions
Author Contributions
Funding
Institutional Review Board Statement
Informed Consent Statement
Data Availability Statement
Conflicts of Interest
References
- Yang, Y.; Yan, H.; Kang, X.; Zhibin, Z. Advances in Application Research of Polycaprolactone. New Chem. Mater. 2011, 39, 13–15. [Google Scholar]
- Lo, H.Y.; Kuo, H.T.; Huang, Y.Y. Application of Polycaprolactone as an Anti-Adhesion Biomaterial Film. Artif. Org. 2010, 34, 648–653. [Google Scholar] [CrossRef] [PubMed]
- Lam, C.X.; Savalani, M.M.; Teoh, S.H.; Hutmacher, D.W. Dynamics of in vitro polymer degradation of polycaprolactone-based scaffolds: Accelerated versus simulated physiological conditions. Biomed. Mater. 2008, 3, 034108. [Google Scholar] [CrossRef] [PubMed]
- Chen, D.R.; Bei, J.Z.; Wang, S.G. Polycaprolactone microparticles and their biodegradation. Polym. Degrad. Stabil. 2000, 67, 455–459. [Google Scholar] [CrossRef]
- Cho, H.S.; Moon, H.S.; Kim, M.; Nam, K.; Kim, J.Y. Biodegradability and biodegradation rate of poly(caprolactone)—Starch blend and poly(butylene succinate) biodegradable polymer under aerobic and anaerobic environment. Waste Manag. 2011, 31, 475–480. [Google Scholar] [CrossRef] [PubMed]
- Lavernia, L.; Brown, W.E.; Wong, B.J.F.; Hua, J.C.; Athanasiou, K.A. Toward tissue-engineering of nasal cartilages. Acta Biomater. 2019, 88, 42–56. [Google Scholar] [CrossRef]
- Bogun, M.; Mikolajczyk, T.; Kurzak, A.; Blazewicz, M.; Rajzer, I. Influence of the as-spun draw ratio on the structure and properties of PAN fibres including montmorillonite. Fibres Text. East. Eur. 2006, 14, 13–16. [Google Scholar]
- Jia, A.; Ee, J.; Teoh, M.; Suntornnond, R.; Chua, C.K. Design and 3D printing of scaffolds and tissues. Engineering 2015, 1, 261–268. [Google Scholar]
- Fanovich, M.A.; Ivanovic, J.; Misic, D.; Alvarez, M.V.; Jaeger, P.; Zizovic, I.; Eggers, R. Development of polycaprolactone scaffold with antibacterial activity by an integrated supercritical extraction and impregnation process. J. Supercrit. Fluids 2013, 78, 42–53. [Google Scholar] [CrossRef]
- Wang, H.; Synatschke, C.; Raup, A.; Jerome, V.; Freitag, R.; Agarwal, S. Oligomeric dual functional antibacterial polycaprolactone. Polym. Chem. 2014, 5, 2453–2460. [Google Scholar] [CrossRef]
- Teo, E.Y.; Ong, S.Y.; Chong, M.S.K.; Zhang, Z.; Lu, J.; Moochhala, S.; Ho, B.; Teoh, S.H. Polycaprolactone-based fused deposition modeled mesh for delivery of antibacterial agents to infected wounds. Biomaterials 2011, 32, 279–287. [Google Scholar] [CrossRef] [PubMed]
- Zhou, Z.; Yao, Q.; Li, L.; Zhang, X.; Wei, B.; Yuan, L.; Wang, L. Antimicrobial Activity of 3D-Printed Poly(ε-Caprolactone) (PCL) Composite Scaffolds Presenting Vancomycin-Loaded Polylactic Acid-Glycolic Acid (PLGA) Microspheres. Med. Sci. Monit. Int. Med. J. Exp. Clin. Res. 2018, 24, 6934–6945. [Google Scholar] [CrossRef]
- Yang, Y.; Zheng, K.; Liang, R.; Mainka, A.; Taccardi, N.; Roether, J.A.; Detsch, R.; Goldmann, W.H.; Virtanen, S.; Boccaccin, A.R. Cu-releasing bioactive glass/polycaprolactone coating on Mg with antibacterial and anticorrosive properties for bone tissue engineering. Biomed. Mater. 2017, 13, 015001. [Google Scholar] [CrossRef] [PubMed]
- Lim, M.M.; Sultana, N. In vitro cytotoxicity and antibacterial activity of silver-coated electrospun polycaprolactone/gelatine nanofibrous scaffolds. 3 Biotech 2016, 6, 211. [Google Scholar] [CrossRef] [PubMed]
- Augustine, R.; Malik, H.N.; Singhal, D.K.; Mukherjee, A.; Malakar, D.; Kalarikkal, N.; Thomas, S. Electrospun polycaprolactone/ZnO nanocomposite membranes as biomaterials with antibacterial and cell adhesion properties. J. Polym. Res. 2014, 21, 347. [Google Scholar] [CrossRef]
- Felice, B.; Sánchez, M.A.; Socci, M.C.; Sappia, L.D.; Gómez, M.I.; Cruz, M.K.; Felice, C.J.; Martí, M.; Pividori, M.I.; Simonelli, G.; et al. Controlled degradability of PCL-ZnO nanofibrous scaffolds for bone tissue engineering and their antibacterial activity. Mater. Sci. Eng. C 2018, 93, 724–738. [Google Scholar] [CrossRef]
- Liu, S.; Zeng, T.H.; Hofmann, M.; Burcombe, E.; Wei, J.; Jiang, R.; Kong, J.; Chen, Y. Antibacterial Activity of Graphite, Graphite Oxide, Graphene Oxide, and Reduced Graphene Oxide: Membrane and Oxidative Stress. ACS Nano 2011, 5, 6971–6980. [Google Scholar] [CrossRef]
- Hu, W.; Peng, C.; Luo, W.; Lv, M.; Li, X.; Li, D.; Huang, Q.; Fan, C. Graphene-Based Antibacterial Paper. ACS Nano 2010, 4, 4317–4323. [Google Scholar] [CrossRef]
- Sabine, S.; Boukherroub, R. Antibacterial activity of graphene-based materials. J. Mater. Chem. B 2016, 4, 6892–6912. [Google Scholar]
- Kurantowicz, N.; Sawosz, E.; Jaworski, S.; Kutwin, M.; Strojny, B.; Wierzbicki, M.; Szeliga, J.; Hotowy, A.; Lipińska, L.; Koziński, R.; et al. Interaction of graphene family materials with Listeria monocytogenes and Salmonella enterica. Nanoscale Res. Lett. 2015, 10, 23. [Google Scholar] [CrossRef]
- Chen, H.; Gao, D.; Wang, B.; Zhao, R.; Guan, M.; Zheng, L.; Zhou, X.; Chai, Z.; Feng, W. Graphene oxide as an anaerobic membrane scaffold and antagonistic effects against pathogenic E. coli and S. aureus. Nanotechnology 2014, 25, 165101. [Google Scholar] [CrossRef] [PubMed]
- Rajzer, I.; Kurowska, A.; Jabłoński, A.; Kwiatkowski, R.; Piekarczyk, W.; Hajduga, M.B.; Kopeć, J.; Sidzina, M.; Menaszek, E. Scaffolds modified with graphene as future implants for nasal cartilage. J. Mater. Sci. 2020, 55, 4030–4042. [Google Scholar] [CrossRef]
- Kalwar, K.; Sun, W.X.; Li, D.L.; Zhang, X.J.; Shan, D. Coaxial electrospinning of polycaprolactone@chitosan: Characterization and silver nanoparticles incorporation for antibacterial activity. React. Funct. Polym. 2016, 107, 87–92. [Google Scholar] [CrossRef]
- López, E.J.; Espinosa, C.L.F.; Donohue, C.A.; Reyes, L.S.Y. Antimicrobial Activity of Silver Nanoparticles in Polycaprolactone Nanofibers against Gram-Positive and Gram-Negative Bacteria. Ind. Eng. Chem. Res. 2015, 55, 12532–12538. [Google Scholar] [CrossRef]
- Calderone, R.A.; Fonzi, W.A. Virulence factors of Candida albicans. Trends Microbiol. 2001, 9, 327–335. [Google Scholar] [CrossRef]
- Xiaoyi, X.; Qingbiao, Y.; Yongzhi, W.; Haijun, Y.; Xuesi, C.; Xiabin, J. Biodegradable electrospun poly(l-lactide) fibers containing antibacterial silver nanoparticles. Eur. Polym. J. 2006, 42, 2081–2087. [Google Scholar]
- Mangadlao, J.D.; Santos, C.M.; Felipe, M.J.L.; Leon, A.C.C.; Rodrigues, D.F.; Advincula, R.C. On the antibacterial mechanism of graphene oxide (GO) Langmuir–Blodgett films. Chem. Commun. 2015, 51, 2886–2889. [Google Scholar] [CrossRef]
- Mayer, L.F.; Wilson, D.; Hube, B. Candida albicans pathogenicity mechanisms. Virulence 2013, 4, 119–128. [Google Scholar] [CrossRef]
- Lowy, F.D. Staphylococcus aureus infections. N. Engl. J. Med. 1998, 339, 520–532. [Google Scholar] [CrossRef]
- Kaper, J.; Nataro, J.; Mobley, H. Pathogenic Escherichia coli. Nat. Rev. Microbiol. 2004, 2, 123–140. [Google Scholar] [CrossRef]

| Staphylococcus aureus ATTC 25923—Initial Density 1.5 × 105 CFU/mL | Escherichia coli ATTC 25922—Initial Density 1.5 × 105 CFU/mL | Candida albicans ATTC 10231—Initial Density 1.5 × 105 CFU/mL | ||||
|---|---|---|---|---|---|---|
| Preparation Tested | The Number of CFU/mL after 17 h of Incubation with the Preparation in Individual Samples | Antibacterial Efficacy (ABE) [%] in Individual Samples | The Number of CFU/mL after 17 h of Incubation with the Preparation in Individual Samples | Antibacterial Efficacy (ABE) [%] in Individual Samples | The Number of CFU/mL after 17 h of Incubation with the Preparation in Individual Samples | Antibacterial Efficacy (ABE) [%] in Individual Samples |
| PCL | 63,300 | 9.57 | 2.1 × 108—confluent growth obtained for each repeat test | 0 | 1000 | 95.98 |
| 51,350 | 26.64 | 0 | 500 | 97.99 | ||
| 49,750 | 28.93 | 0 | 350 | 98.59 | ||
| 2980 | 57.43 | 0 | 300 | 98.8 | ||
| PCL/GNP_0.5 | 12,050 | 82.78 | 2.1 × 108—confluent growth obtained for each repeat test | 0 | 11,550 | 53.61 |
| 8050 | 88.5 | 0 | 10,150 | 59.24 | ||
| 4750 | 93.21 | 0 | 5500 | 77.91 | ||
| 900 | 98.71 | 0 | 4300 | 82.73 | ||
| PCL/GNP_5 | 7.0 × 104—confluent growth obtained for each repeat test | 0 | 2.1 × 108—confluent growth obtained for each repeat test | 0 | 29,500 | 0 |
| 0 | 0 | 25,500 | 0 | |||
| 0 | 0 | 25,250 | 0 | |||
| 0 | 0 | 25,000 | 0 | |||
| PCL/GNP_10 | 7.0 × 104—confluent growth obtained for each repeat test | 0 | 2.1 × 108—confluent growth obtained for each repeat test | 0 | 5.0 × 104—confluent growth obtained for each repeat test | 0 |
| 0 | 0 | 0 | ||||
| 0 | 0 | 0 | ||||
| 0 | 0 | 0 | ||||
Publisher’s Note: MDPI stays neutral with regard to jurisdictional claims in published maps and institutional affiliations. |
© 2022 by the authors. Licensee MDPI, Basel, Switzerland. This article is an open access article distributed under the terms and conditions of the Creative Commons Attribution (CC BY) license (https://creativecommons.org/licenses/by/4.0/).
Share and Cite
Hajduga, M.B.; Bobinski, R.; Dutka, M.; Bujok, J.; Cwiertnia, M.; Pajak, C.; Kurowska, A.; Rajzer, I. The Influence of Graphene Content on the Antibacterial Properties of Polycaprolactone. Int. J. Mol. Sci. 2022, 23, 10899. https://doi.org/10.3390/ijms231810899
Hajduga MB, Bobinski R, Dutka M, Bujok J, Cwiertnia M, Pajak C, Kurowska A, Rajzer I. The Influence of Graphene Content on the Antibacterial Properties of Polycaprolactone. International Journal of Molecular Sciences. 2022; 23(18):10899. https://doi.org/10.3390/ijms231810899
Chicago/Turabian StyleHajduga, Maciej B., Rafał Bobinski, Mieczysław Dutka, Jan Bujok, Michał Cwiertnia, Celina Pajak, Anna Kurowska, and Izabella Rajzer. 2022. "The Influence of Graphene Content on the Antibacterial Properties of Polycaprolactone" International Journal of Molecular Sciences 23, no. 18: 10899. https://doi.org/10.3390/ijms231810899
APA StyleHajduga, M. B., Bobinski, R., Dutka, M., Bujok, J., Cwiertnia, M., Pajak, C., Kurowska, A., & Rajzer, I. (2022). The Influence of Graphene Content on the Antibacterial Properties of Polycaprolactone. International Journal of Molecular Sciences, 23(18), 10899. https://doi.org/10.3390/ijms231810899

